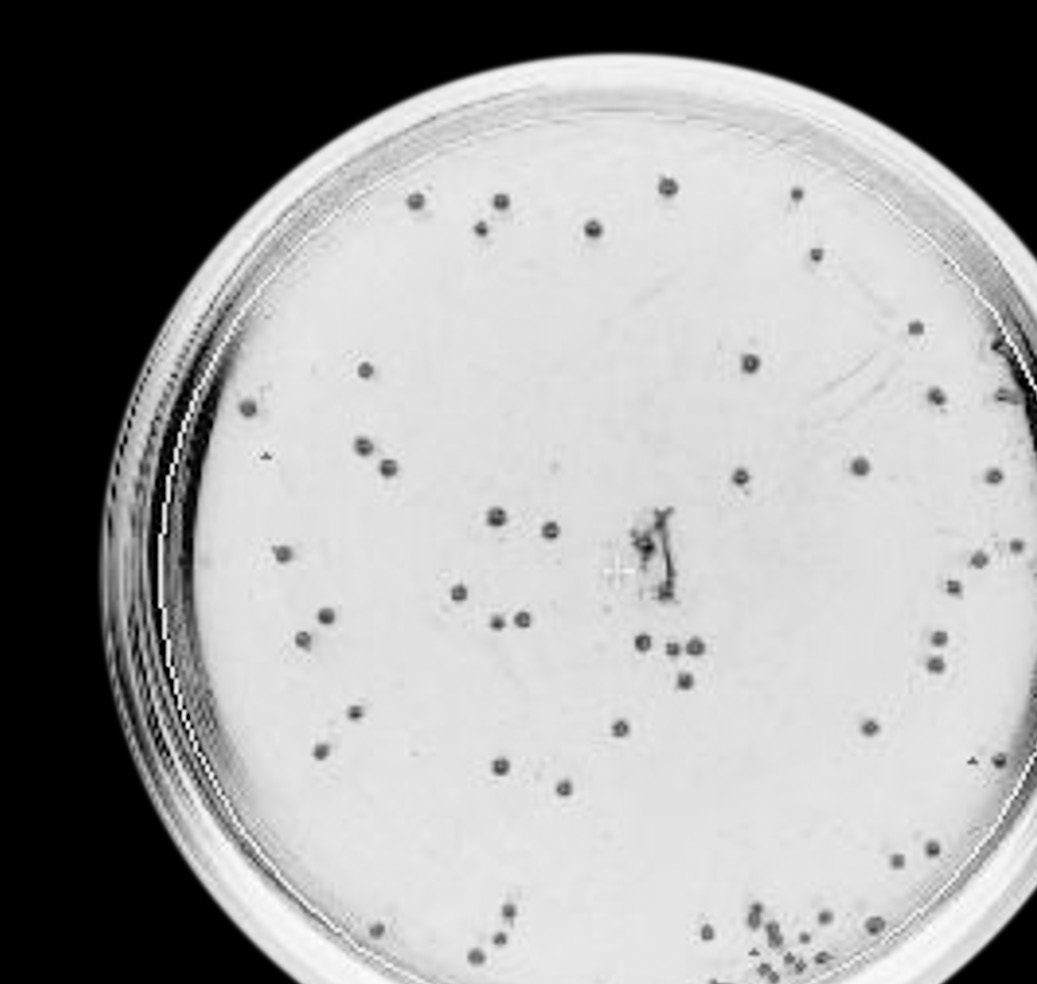
Embedded figure page 5

- The growth of non‑pathogenic Escherichia coli bacteria were studied in a microbiology laboratory at different temperatures with the antibiotic ampicillin. The number of bacterial colonies that grew were counted, and the mean and standard deviations calculated for five replicates per temperature. At 25 °C, the mean number of colonies counted was 70 ± 8. The Petri dish shows the results obtained in one of the replicates at this temperature.
(a) State the dependent variable in this experiment. [1]
(b) Explain the need for replicates in this experiment. [2]
(c) Suggest one reason for the presence of bacterial colonies despite the use of the antibiotic ampicillin. [1]